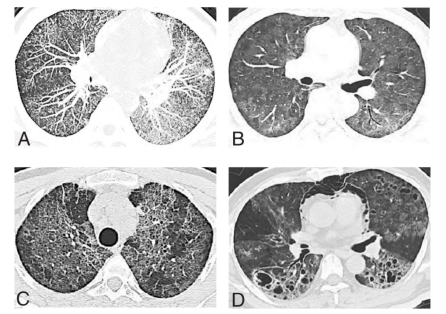
图片

编者按:肺孢子菌肺炎是一种由耶氏肺孢子菌引起的间质性浆细胞性肺炎,为条件性肺部感染性疾病,通常发生于免疫系统受损的患者。在全球华人肾脏病学会和广东省医学会共同主办、广东省医学会肾脏病学分会承办的第四届全球华人肾脏病学大会暨2023年广东省医学会肾脏病学学术年会(ICCN 2023)上,山西省人民医院周晓霜教授从一例免疫抑制剂治疗后发热、胸痛的年轻男性IgA肾病患者病例出发,抽丝剥茧,对耶氏肺孢子菌肺炎的病因、诊断和治疗进行了详细概述。
病例介绍
年轻男性IgA肾病患者为何免疫抑制剂治疗后发热、胸痛?
患者男性,34岁。主诉:发现血肌酐升高2年,发热7天,加重3天。
既往史:发现血压增高2年,最高达180/120 mmHg,目前口服“氯沙坦钾片50 mg 1次/日、苯磺酸氨氯地平片5 mg 2次/日,血压控制欠佳。
现病史:患者2年前(2020年)因血压增高达180/120 mmHg,就诊于山西省某市人民医院,发现尿蛋白3+、尿潜血2+:血肌酐141 μmol/L,诊断为“慢性肾脏病”,给予“硝苯地平控释片30 mg/日2次、氯沙坦钾片50 mg/日1次”等治疗。间断复查尿常规:尿蛋白、尿潜血均波动于1+ ~ 2+。肾功能:血肌酐波动于180~235 μmol/L。
患者8月前就诊于山西省人民医院,复查血肌酐231 μmol/L,查:尿蛋白2+,24 h尿蛋白定量2.33 g,血白蛋白38.8 g/L、Scr 270 μmol/L、BUN 2.43 mmol/L.UA 582 μmol/L,腹部彩超示:双肾大小正常,双肾实质回声增强,行肾穿刺活检示:“局灶增生坏死性及硬化性IgA肾病(M0E1S1T1C1)”,建议给予“醋酸泼尼松40 mg/日、吗替麦考酚酯0.5 g,2次/日)”。患者拒绝。5月余前就诊于某市非公立医院,给予甲强龙320 mg冲击3天,续以甲泼尼龙片40 mg/日维持冶疗,同时联合吗替麦考酚酯分散片0.75 mg口服2次/日治疗。
患者2月前(2022年9月5日)调整为甲泼尼龙片24 mg/日1次,吗替麦考酚酯分散片0.75 g/日2次:1月前(2022年10月5日),调整为甲泼尼龙片20 mg/日1次,吗替麦考酚酯分散片0.5 g/日2次:10天前(2022年10月20日)调整为甲泼尼龙片16 mg/日1次,吗替麦考酚酯分散片0.5 g/日2次。
患者7天前无明显诱因出现体温增高(体温不详)偶有胸痛,无咳嗽咳痰,无腹痛、腹泻,无尿频、尿急、尿痛,与就诊医院联系后停用吗替麦考酚酯,加用复方磺胺甲噁唑片2片,每日2次,3天前患者上述症状加重,体温最高达38.5℃,甲泼尼龙片减量至12 mg/日1次,遂于急诊就医,考虑肺部感染并收入山西省人民医院肾内科。
哥氏银染色法、甲苯胺蓝-D染色法检测肺泡灌洗液显示耶氏肺孢子感染。血液、肺泡灌洗液宏基因组显示耶氏肺孢子感染。
耶氏肺孢子菌是什么?患者为何会发生耶氏肺孢子感染?耶氏肺孢子菌肺炎应该怎么治疗?
耶氏肺孢子菌肺炎的病因、诊断、治疗
耶氏肺孢子菌肺炎的病因
耶氏肺孢子菌肺炎又称为肺孢子菌肺炎(pneumocystis pneumonia,PCP),多见于免疫缺陷患者,是由肺孢子菌引起的肺部感染性疾病。耶氏肺孢子菌(peneumocystis jiroveci,PJ)广泛存在于人和哺乳动物肺组织内,是一种机会性致病菌。当宿主免疫功能低下时,可诱发PCP,PCP一旦发生,病情进展迅速,不经治疗,几乎100%死亡。
免疫抑制剂治疗后可引起免疫缺陷,常用的免疫抑制剂包括:泼尼松,他克莫司、环孢素A等钙调神经蛋白抑制剂,吗替麦考酚酯,利妥昔单抗。近年,随着器官移植和免疫抑制剂的广泛应用,非获得性免疫缺陷综合征(AIDS)PCP患者呈增多趋势[1]。与艾滋病(AIDS)患者相比,非艾滋病患者合并PCP发病急、进展快、易误诊,且病死率高[2]。非艾滋病合并耶氏孢子菌的病死率已达30%~50%[3-5]。此外,不同于AIDS-PCP患者仅有CD4+ T减低,该类患者起病后CRP、PCT、IL-6等炎症指标快速升高,肺部氧合情况更差,CPR及有创机械通气、院内死亡率更高[2]。
诊断标准
(1)症状:发热、干咳和渐进性呼吸困难是PJP的主要临床症状。
(2)影像学检查:典型影像学表现包括:粟粒结节、磨玻璃影、“碎石路”征、肺气囊、纵隔气胸(图1)。在早期呈弥漫性肺泡和间质浸润性阴影,迅速融合而成为广泛肺实变,可见支气管充气征,一般不累及肺尖、肺底和肺外带。
图1. 耶氏肺孢子菌肺炎不同时期肺部CT影像(A粟粒结节;B磨玻璃阴影;C“碎石路”征;D肺气囊、纵隔气肿)
(3)实验室检查:CKD-PJP患者血液中性粒细胞计数、CPR、PCT、IL-6、血清真菌G较高,提示肺泡巨噬细胞吞噬PJ后释放1,3-β-D葡聚糖,导致强烈炎症反应。需注意,1,3-β-D葡聚糖水平升高提示治疗失败或合并另一种真菌感染,而水平下降并不能明确预测治疗成功[6]。
(4)病原学和组织学检查:痰或导痰标本以及BAL应用吉姆萨染色法显示子孢子(红色);应用哥氏银染色法、甲苯胺蓝-D染色法显示包囊壁(分别呈黑色和蓝色)仍然是目前常用和经典的PCP病原学诊断方法。
伴有以下临床症状和体征,可确定为PCP高危:呼吸困难和/或咳嗽、发热(偶尔可缺如)低氧血症(偶尔可缺如)、胸痛(罕见,气胸所致)、放射学改变符合PCP(首选胸部CT扫描)伴有或不伴有原因未明的血清乳酸脱氢酶升高。
非HPV患者PCP如有下列因素,一般预后不良:基础疾病控制不好、ECOGPS>2、长期使用糖皮质激素、抗PCP治疗的延迟、低白蛋白血症、合并HSV(单纯疱疹病毒肺炎)或CMV(巨细胞病毒)感染、BAL高中性粒细胞计数、高APACHE-II(急性生理与慢性健康评分)或SAPS-II(简化急性生理学评分)。
治疗方案
由于延迟治疗可增加机械通气的概率和死亡率,因此及时启动PCP特异性治疗至关重要。高度怀疑的患者治疗时机应当不受实验室检查结果而延迟。
甲氧苄啶(TMP)-磺胺甲恶唑(SMZ)为抗PCP的一线药物(表1)。近年伴随着二氢叶酸合成酶基因突变,对TMP-SMZ耐药的PCP增多。TMP-SMZ联合使用卡泊芬净可以抑制PJ的整个生命周期,对抗PJ时可以起到协同效应。
表1. PCP一线治疗方案

表2. PCP二线治疗方案

需注意,应用伯安奎时,患者应检查是否存在葡萄糖-6-磷酸脱氢酶缺乏症。
我国艾滋病诊疗指南建议中重度PCP患者早期可应用糖皮质激素[7]。而非HIV患者的PCP诊疗指南以及多个荟萃分析对是否需要糖皮质激素治疗PCP尚有争议。但该类患者肺间质炎性渗出较重,早期使用糖皮质激素可减轻炎症反应、缓解肺纤维化、改善肺部氧合功能,有助于缓解患者的高热,改善呼吸窘迫,避免气压伤。
治疗效果评价
非HPV患者PCP治疗过程中的预后不良因素包括:使用血管收缩剂/休克;需要大剂量糖皮质激素治疗;呼吸衰竭/大流量吸氧;机械通气;有急性呼吸窘迫综合征(ARDS);在第8天时症状加重(疾病演变过程)。
治疗第3~5天可评估是否早期临床恶化;治疗第8天在临床没有改善或发生动脉血气分析证明的呼吸功能恶化,应当怀疑治疗失败;经8天治疗失败的患者应当再行支气管镜检查和支气管肺泡灌洗以证实有无合并感染;治疗第13天(中位时间),57%的患者通过复查胸部CT可观察到病情改善。需注意,由于系统抗PCP治疗后的数天或数周仍可以从支气管肺泡灌洗液中仍然能检出耶氏肺孢子菌,因此不能用耶氏肺孢子菌的PCR阳性结果来解释治疗失败。
患者治疗经过
结合患者病史、实验室检查、影像学、病理检查结果以及既往用药,入院后体温37度,给予复方磺胺甲恶唑片2片/Bid、头孢哌酮/舒巴坦1.5 g/q12h、静注人免疫球蛋白10 g/日。
由于患者感染指标持续增高,且胸部CT较前加重,目前抗感染方案效果欠佳,G试验>600 pg/ml,临床上细菌、真菌(曲霉菌等)、病毒(如巨细胞病毒)均不能除外;完善痰培养、TORCH、新冠病毒、流感病毒、真菌培养、支气管镜检查(送培养、NGS、六胺银染色等),治疗方案调整为:复方磺胺甲恶唑片2片/Bid、卡泊芬净50 mg/qd、美罗培南0.5 g/q12h、莫西沙星0.4/qd、更昔洛韦0.25 g/bid。
六安银染色阳性(+),患者突发胸憋气短、血氧饱和度持续下降,加用激素治疗(甲泼尼龙40 mg/d);血液和肺泡灌洗液病原宏基因组学检测提示肺孢子菌感染,抗感染方案调整为:复方磺胺甲恶唑片2片/Bid、卡泊芬净50 mg/qd,激素减量(甲泼尼龙减为20 mg/d)。
2022年11月17日复查胸部CT提示典型PJP的CT表现磨玻璃样病变较少,反映混合感染的斑片状阴影病变较多。患者出院后2、4、5、8个月时复查,实验室检查结果逐渐好转。目前患者已停用所有激素及免疫抑制剂,血压控制良好。
小结
肺孢子菌肺炎是一种由耶氏肺孢子菌引起的严重感染性疾病,通常会发生在免疫系统受损的患者,如艾滋病或长期口服免疫抑制剂(肾脏病、接受器官移植等)的患者。肺孢子菌肺炎的治疗需要综合考虑患者的免疫状况和临床情况,治疗要尽快启动。早期诊断对提高患者的生存率至关重要。需特别注意,在肺孢子菌肺炎的治疗过程中如果患者出现病情反复要警惕合并其他感染的可能。
专家简介
周晓霜 教授
山西省人民医院肾内科

参考文献
1. 李晓亮 , 马希涛 . 国内近 5 年肺孢子菌肺炎 4153 例分析 . 医药论坛志 , 2014, 35(5):61-63.2. Monnet X,Vidal-Petiot E, Osman D,et al.Critical care management and outcome of severe Pneumocystis pneumonia in patients with and without HIV infection〔J〕.Crit Care,2008,12(1):1-9. 3.Bienvenu AL,Traore K,Plekhanova I,et al. Pneumocystis pneumonia suspected cases in 604 non-HIV and HIV patients 〔J〕. Int J Infect Dis,2016,46:11-17. 4.Green H,Paul M,Vidal L,et al.Prophylaxis for Pneumocystis pneumonia ( PCP) in non-HIV immunocompromised patients〔J〕. Cochrane Database Syst Rev,2007,3:1-47. 5.黄絮,翁利,易丽,等.非 HIV 免疫抑制患者肺孢子菌肺炎合并急性呼吸衰竭的临床特征〔J〕. 中华医学杂志,2016,96(38):3057-3061.6. Maschmeyer G, et al. ECIL guidelines for treatment of Pneumocystis jirovecii pneumonia in non-HIV-infected haematology patients. J Antimicrob Chemother. 2016 Sep;71(9):2405-13. doi: 10.1093/jac/dkw158. Epub 2016 May 12. PMID: 27550993.7. 中华医学会感染病学分会艾滋病丙型肝炎学组, 中国疾病预防控制中心. 中国艾滋病诊疗指南(2021年版). 中华内科杂志,2021,60(12): 1106-1128.